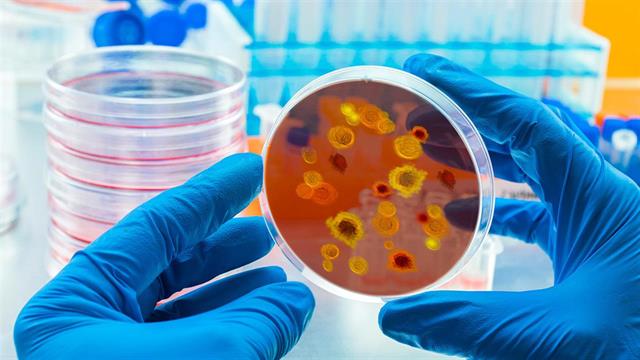
Ο μυστηριώδης πυρετός της τομάτας

Οι ερευνητές - επιστήμονες στην Ινδία προβληματίζονται για την αιτία του λεγόμενου "πυρετού της τομάτας" ή "γρίπης της ντομάτας", μιας ασθένειας που έχει εμφανιστεί σε περισσότερα από 100 παιδιά. Δεν είναι σαφές αν πρόκειται για έναν νέο τύπο ιογενούς λοίμωξης ή για το αποτέλεσμα άλλων ιογενών λοιμώξεων.
Οι επιστήμονες γράφουν στην επιθεώρηση "Lancet Respiratory Medicine" ότι ο "πυρετός της ντομάτας" μπορεί επίσης να είναι συνέπεια των τροπικών ιογενών λοιμώξεων chikungunya ή dengue fever ή μια παραλλαγή του αφθώδους πυρετού των χεριών και των ποδιών.
Εντούτοις η νόσος είναι αυτοπεριοριζόμενη και δεν συνιστά απειλή για τη ζωή, προσθέτουν οι επιστήμονες. Όμως, με βάση την εμπειρία από την πανδημία κορωνοιού, θα πρέπει να παραμείνουμε σε επαγρύπνηση.
Μέχρι στιγμής, έχουν αναφερθεί κρούσματα από 3 ινδικές πολιτείες, αναφέρει η έκθεση. Μόνο στην πολιτεία Kerala, όπου πρωτοεμφανίστηκε η λοίμωξη, τουλάχιστον 82 παιδιά κάτω των 5 ετών είχαν προσβληθεί μέχρι τα τέλη Ιουλίου. Στην πολιτεία Odisha, η ασθένεια έχει εντοπιστεί σε 26 παιδιά ηλικίας μεταξύ 1 και 9 ετών.
Σύμφωνα με το άρθρο, τα κύρια συμπτώματα, παρόμοια με εκείνα του chikungunya, περιλαμβάνουν υψηλό πυρετό, έντονο πόνο στις αρθρώσεις και δερματικά συμπτώματα, τα οποία δίνουν και το όνομά της στην ασθένεια: πρόκειται για κόκκινες και επώδυνες φουσκάλες που σταδιακά επεκτείνονται σε μέγεθος τομάτας και μπορούν να προκαλέσουν ερεθισμό στο δέρμα.
Άλλα πιθανά συμπτώματα, όπως και σε άλλες ιογενείς λοιμώξεις, περιλαμβάνουν κόπωση, ναυτία, έμετο, διάρροια, αφυδάτωση ή οίδημα των αρθρώσεων.
Μέχρι στιγμής δεν υπάρχει κάποια συγκεκριμένη θεραπεία. Εκτός από την ανάπαυση και την επαρκή ενυδάτωση, η θεραπεία περιλαμβάνει απομόνωση για 5-7 ημέρες μετά την έναρξη των συμπτωμάτων για την πρόληψη της εξάπλωσης.
Ένα σφουγγάρι βουτηγμένο σε ζεστό νερό βοηθά στην ανακούφιση κατά των δερματικών συμπτωμάτων και των ερεθισμών. Άλλες επιλογές περιλαμβάνουν τη χορήγηση παρακεταμόλης για τη μείωση του πυρετού και την ανακούφιση από τον πόνο.
Πηγές:
Lancet Respiratory Medicine
Ειδήσεις υγείας σήμερα
Γεωργιάδης για πρόσκληση Τάιλερ Μακμπέθ: Στη διάθεση του κ. Κασσελάκη να ανταλλάξουμε απόψεις για την Υγεία
Η Αναστασία Κοτανίδου νέα πρόεδρος του ΚΕΣΥ
Το νέο Διοικητικό Συμβούλιο της Ελληνικής Ακτινολογικής Εταιρείας
Αισθητήρας - επίθεμα ανιχνεύει πιο συχνά τον πυρετό σε χειρουργημένους ασθενείς
Αισθητήρας - επίθεμα ανιχνεύει πιο συχνά τον πυρετό σε χειρουργημένους ασθενείς Πυρετικοί σπασμοί στα παιδιά: Τι πρέπει να γνωρίζουν οι γονείς
Πυρετικοί σπασμοί στα παιδιά: Τι πρέπει να γνωρίζουν οι γονείς Αιμορραγικός πυρετός Κριμαίας - Κογκό: Τι δείχνουν οι αναλύσεις στη Λάρισα
Αιμορραγικός πυρετός Κριμαίας - Κογκό: Τι δείχνουν οι αναλύσεις στη Λάρισα Αιμορραγικός πυρετός Κριμαίας Κογκό: Το "ένοχο" είδος τσιμπουριού - Τι να προσέχουμε
Αιμορραγικός πυρετός Κριμαίας Κογκό: Το "ένοχο" είδος τσιμπουριού - Τι να προσέχουμε Αιμορραγικός πυρετός Κριμαίας Κογκό: Συμπτώματα και κίνδυνοι
Αιμορραγικός πυρετός Κριμαίας Κογκό: Συμπτώματα και κίνδυνοι ΕΟΔΥ: Κρούσμα αιμορραγικού πυρετού Κριμαίας, Κονγκό - Πέθανε ο 70χρονος ασθενής
ΕΟΔΥ: Κρούσμα αιμορραγικού πυρετού Κριμαίας, Κονγκό - Πέθανε ο 70χρονος ασθενής ΟΟΣΑ: Ένας στους πέντε Ευρωπαίους πάσχει από ψυχική διαταραχή
ΟΟΣΑ: Ένας στους πέντε Ευρωπαίους πάσχει από ψυχική διαταραχή Άσκηση με βάρη μειώνει τον κίνδυνο καρδιακών παθήσεων στις γυναίκες [μελέτη]
Άσκηση με βάρη μειώνει τον κίνδυνο καρδιακών παθήσεων στις γυναίκες [μελέτη] ΟΙΚΟΘΕΝ: Τηλεϊατρική μέσω tablet και πιεσόμετρο με bluetooth στους ασθενείς
ΟΙΚΟΘΕΝ: Τηλεϊατρική μέσω tablet και πιεσόμετρο με bluetooth στους ασθενείς Ειρήνη Αγαπηδάκη: "Είχα φτάσει 108 κιλά στην παιδική μου ηλικία"
Ειρήνη Αγαπηδάκη: "Είχα φτάσει 108 κιλά στην παιδική μου ηλικία" Ρύζι, πατάτες και ζυμαρικά: Ποιο είναι χειρότερο για το σάκχαρο;
Ρύζι, πατάτες και ζυμαρικά: Ποιο είναι χειρότερο για το σάκχαρο; Με ποιες τροφές να συνδυάζω ρύζι, πατάτες και ζυμαρικά για να μην αυξάνεται απότομα το σάκχαρο
Με ποιες τροφές να συνδυάζω ρύζι, πατάτες και ζυμαρικά για να μην αυξάνεται απότομα το σάκχαρο Καρπούζι: Ποια είναι τα οφέλη του στην υγεία
Καρπούζι: Ποια είναι τα οφέλη του στην υγεία Pharmathen: Βαθιά κρίση και μηδενισμός αποτίμησης από funds της Partners
Pharmathen: Βαθιά κρίση και μηδενισμός αποτίμησης από funds της Partners Ισχυρή πρωτιά της ΔΗΚΙ στις εκλογές του Ιατρικού Συλλόγου Αθηνών - Ρεκόρ συμμετοχής
Ισχυρή πρωτιά της ΔΗΚΙ στις εκλογές του Ιατρικού Συλλόγου Αθηνών - Ρεκόρ συμμετοχής Ιατρικός Σύλλογος Θεσσαλονίκης: Σαρωτική επικράτηση της ΕΝΟ.ΣΥ. - Ν.Ι.Κ.Ι.
Ιατρικός Σύλλογος Θεσσαλονίκης: Σαρωτική επικράτηση της ΕΝΟ.ΣΥ. - Ν.Ι.Κ.Ι. Φαρμακοβιομηχανίες σκέφτονται να χτυπήσουν την πόρτα της Εθνικής Αρχής Διαφάνειας
Φαρμακοβιομηχανίες σκέφτονται να χτυπήσουν την πόρτα της Εθνικής Αρχής Διαφάνειας Οι απρόσμενες συνέπειες της ολοκληρωτικής παράλειψης της ζάχαρης από τη διατροφή [μελέτη]
Οι απρόσμενες συνέπειες της ολοκληρωτικής παράλειψης της ζάχαρης από τη διατροφή [μελέτη]